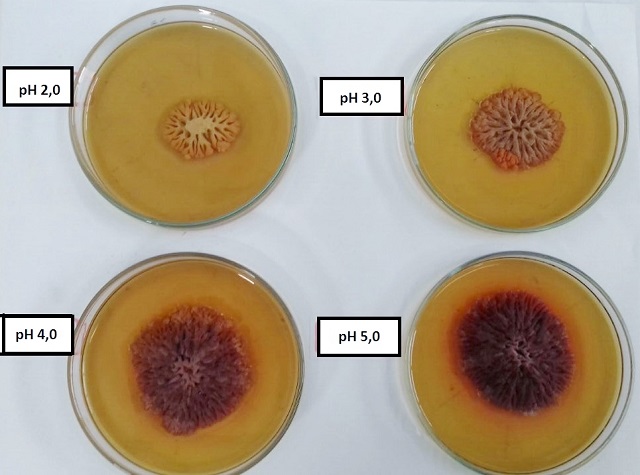

Realizado em Goiânia/GO, de 19 a 21 de Setembro de 2016.
ISBN: 978-85-85905-20-0
TÍTULO: INFLUÊNCIA DO PH NA PRODUÇÃO DE PIGMENTOS PRODUZIDOS POR Monascus ruber MEDIANTE UTILIZAÇÃO DE LACTOSE COMO SUBSTRATO
AUTORES: Pires Vital da Costa, J. (UNIVERSIDADE FEDERAL DE GOIÁS) ; Fernanda Dias de Oliveira, C. (UNIVERSIDADE FEDERAL DE GOIÁS) ; Denner Bernardes de Araújo, W. (UNIVERSIDADE FEDERAL DE GOIÁS) ; Vendruscolo, F. (UNIVERSIDADE FEDERAL DE GOIÁS)
RESUMO: O presente estudo buscou avaliar a velocidade de crescimento radial do Monascus
ruber CCT 3802 em cultivo sólido contendo lactose sob diferentes condições de pH.
As velocidades de crescimento radial obtidas variaram de 0,0463 (pH 2,0) a 0,0726 mm
h-1 (pH 4,0), o que corresponde a um aumento de 157% na velocidade,
demonstrando que é possível dobrar a velocidade de crescimento do micro-organismo e,
consequentemente, sua produção de pigmentos, apenas ajustando-se o pH do meio.
Monascus ruber apresentou adaptação favorável ao seu desenvolvimento na presença
de lactose, desde que submetido a pH acima de 4,0, condição em que obteve-se maior
crescimento da colônia. Tal estudo sugere a utilização de resíduos agroindustriais
contendo lactose para a produção de biopigmentos.
PALAVRAS CHAVES: Lactose; Monascus ruber; biopigmentos
INTRODUÇÃO: A escolha e aquisição dos alimentos está intimamente relacionada aos
primeiros atributos sensoriais, como o aroma, o sabor e a textura. As cores
são adicionadas aos alimentos, principalmente, para restituir a aparência
original, tornar o alimento visualmente mais atraente, conferir coloração
aos desprovidos de cor e reforçar as cores presentes nos alimentos (WIBOWO
et al., 2015). Estudos demonstram a relação do consumo excessivo de corantes
sintéticos com reações alérgicas, hiperatividade em crianças e problemas
respiratórios (NETTO, 2009; ABEROUMAND, 2011).
Pouco ainda se sabe sobre a utilização de pigmentos produzidos por micro-
organismos, por isso, a produção biotecnológica para obtenção dos
biopigmentos naturais em grande escala têm sido alvo de estudos no mundo
científico. Dentre os micro-organismos produtores de pigmentos destaca-se o
Monascus, que possui a capacidade de produzir pigmentos amarelo, laranja e
vermelho (MAPARI et al., 2005).São fungos filamentosos que possuem
capacidades extremas de adaptação. Embora, cresçam em baixo conteúdo de
umidade, o cultivo sólido é afetado pelas composições dos meios, fontes de
nitrogênio, concentração de oxigênio e o valor inicial do pH no sistema, o
qual normalmente é de 4,0 a 7,0. Portanto, a escolha de uma boa fonte de
substrato é importante no sucesso do crescimento dos micro-organismos. O
substrato ideal é aquele que supre todos os nutrientes necessários aos
fungos para sua função ótima (PANDEY et al, 2001; XU et al., 2006).
O presente estudo busca, deste modo, evidenciar a lactose como substrato sob
diferentes condições de pH para a produção de pigmentos naturais,
determinando a velocidade de crescimento radial pelo fungo filamentoso
Monascus ruber CCT 3802 em cultivo sólido.
MATERIAL E MÉTODOS: A presente pesquisa foi realizada no Laboratório de Microbiologia da Escola de
Agronomia da Universidade Federal de Goiás. O micro-organismo utilizado foi o fungo
filamentoso Monascus ruber CCT 3802, obtido da Coleção de Culturas Tropicais
da
Fundação André Tosello (Campinas, SP), mantido em ágar dextrose de batata (PDA) ou
ágar extrato de malte (MEA).A determinação da velocidade do crescimento radial
baseou-se na metodologia proposta por Gabiatti et al. (2006), seguindo algumas
modificações de acordo com as condições experimentais. O procedimento realizou-se em
meio de cultivo MEA adicionado de 10 g L-1 de lactose e variações de pH
de 2,0 a 5,0, utilizando-se soluções de HCl ou NaOH. Os meios de cultivo contendo
lactose também foram previamente autoclavados a 121°C por 15 minutos. A velocidade
de crescimento radial das colônias cultivadas nos meios utilizados foi determinada
pela declividade da regressão linear, conforme a Equação 1. r(t) = a +
VCR . t (1) Em que r(t) é o raio da colônia (mm), a é o coeficiente
linear, dado pelo raio do
objeto inoculador, VCR é a velocidade de crescimento radial
(mm.h-1) e t é o tempo de cultivo(h).
Para as diferentes velocidades obtidas para os diferentes meios analisados, foram
comparadas as declividades das retas em gráficos, utilizando-se o software Microsoft
Excel® 2010. Para verificar se houve diferença significativa entre as velocidades
obtidas das curvas de regressão, foi utilizado o teste-t pelo software STATISTICA
7.1.
RESULTADOS E DISCUSSÃO: A Figura 1 apresenta as curvas de crescimento radial do M. ruber sob
diferentes valores de pH no meio de cultivo. A maior velocidade de crescimento
radial do M. ruber foi obtida quando cultivado sob pH 4,0 (0,0726 +
0,0033 mm) e a menor, em pH 2,0 (0,0463 + 0,0034 mm), o que corresponde a um
crescimento de 1,74 mm dia-1 e 1,11 mm dia-1, respectivamente.
A variação de crescimento entre o menor valor e o maior valor corresponde a um
aumento de 157% na velocidade, demonstrando que é possível dobrar a velocidade de
crescimento do micro-organismo e, consequentemente, sua produção de pigmentos,
apenas ajustando-se o pH do meio.
Para avaliar se houve diferença significativa entre as velocidades de crescimento
foi aplicada a análise de variância (ANOVA). O valor de F calculado foi de 8221,89,
valor esse superior ao valor de F tabelado (F3,12 = 83,63), podendo-se
afirmar, portanto, que há diferença significativa entre as curvas obtidas, ao nível
de significância de 0,05. Assim, para identificar o quanto as amostras diferenciam-
se significativamente, aplicou-se o teste-t ao nível de confiança de 95%. Houve
crescimento do micro-organismo para todas as variações de pH estudadas e, de acordo
com o teste de Tukey, há diferença significativa entre as velocidades de crescimento
do fungo. No entanto, observa-se que, embora a velocidade de crescimento do fungo
tenha sido maior para condições de pH 4,0, não há diferença significativa de
crescimento das colônias para condições de pH 4,0 e 5,0 (p ≤ 0,05).
A Figura 2 apresenta o aspecto visual das colônias de M. ruber observado
neste estudo. É possível identificar que as colônias em pH 4,0 e 5,0 obtiveram
crescimento semelhante após 14 dias de incubação.
Figura 1

Curvas de crescimento radial das colônias de M. ruber
cultivadas em meio de cultivo contendo lactose, sob
diferentes valores de pH.
Figura 2
Aspecto visual das colônias de Monascus ruber CCT 3802
cultivadas em meio de cultivo contendo lactose (10 g L-
1), sob diferentes valores de pH.
CONCLUSÕES: Monascus ruber apresentou adaptação favorável ao seu desenvolvimento na presença de
lactose, desde que submetido a valor de pH acima de 4,0, condição em que obteve-se
maior crescimento da colônia. Ressalta-se, portanto, que condições variáveis de pH e
substrato influenciam diretamente o crescimento e produção de pigmentos por M. ruber.
Meio de cultivo contendo lactose sugere que o fungo é capaz de produzir enzimas
(lactase) capazes de hidrolisar esse açúcar redutor, possibilitando a utilização dessa
fonte de carbono.
AGRADECIMENTOS:
REFERÊNCIAS BIBLIOGRÁFICA: ABEROUMAND, A. A Review Article on Edible Pigments Properties and Sources as natural Biocolorants in Foodstuff and Food Industry. World Journal of Dairy & Food Sciences, v.6, n.1, p.71-78, 2011.
GABIATTI, JR. C.; VENDRUSCOLO, F.; PIAIA, J. C. Z.; RODRIGUES, R. C.; DURRANT, L. R.; COSTA, J. A. V. Radial growth rate as a tool for the selection of filamentous fungi for use in bioremediations. Brazilian Archives of Biology and Technology, v.49, p.29-34, 2006.
GARBER, L. L.; HYATT, E.M.; STARR, R. G. The effects of food color on perceived flavor. Journal of Marketing: Theory and Pratice, p. 60-72, 2000.
KONGRUANG, S. Growth kinetics of biopigment production by Thai isolated Monascus purpureus in a stirred tank bioreactor. Journal of Industrial Microbiology & Biotechnology, v. 2, n. 12, p. 93-99, 2011.
KUMAR, A.; VISHWAKARMA, H. S.; SINGH, J.; DWVEDI, S.; KUMAR, M. Microbial pigments: production and their applications in various industries. International journal of pharmaceutical, chemical and biological sciences, v.5, n.1, p. 203-212, 2015.
MAPARI, S. A. S.; NIELSEN, K. F.; LARSSEN, T. O.; FRISVAD, J. C.; MEYER, A. S.; THRANE, U. Exploring fungal biodiversity for the production of water-soluble pigments as potencial natural food colorants. Current Opinion in Biotechnology, v. 16, p. 231-238, 2005.
NETTO, R. C. M. Dossiê corantes. FOOD INGREDIENTS BRASIL, n. 9, 2009. Disponível em: <http://www.revista-fi.com/materias/106.pdf>. Acesso em: 18 julho 2016.
PANDEY, A.; SOCCOL, C. R.; RODRIGUEZ-LEON, J. A.; NIGAM, P. Solid-State Fermentation in Biotechnology: fundamentals and applications. New Delhi: Asiatech, 2001. 221p.
VENDRUSCOLO, F.; PITOL, L. O.; CARCIOFI, B. A.; MORITZ, D. E.; LAURINDO, J. B.; SCHMIDELL, W.; NINOW, J. L.; BARBI, I. Construction and application a vane system in a rotational rheometer for determination of the rheological properties of Monascus ruber CCT 3802. Journal of Biomolecular, v. 24, p. 29-35, 2010.
VENDRUSCOLO, F.; SCHMIDELL, W.; MORITZ, D. E.; BÜHLER, R. M. M.; DE OLIVEIRA, D.; NINOW, J. L. Isoelectric point of amino acid: Importance for Monascus pigment production. Biocatalysis and Agricultural Biotechnology, v. 5, p. 179–185, 2016.
WIBOWO, S.; VERVOORT, L.; TOMIC, J.; SANTIAGO, J. S.; LEMMENS, L.; PANOZZO, A.; XU, B. J.; JIA, X. Q.; GU, L. J.; SUNG, C. K. Review on the qualitative and quantitative analysis of the mycotoxin citrinin. Food Control, v.17, n.4, p.271-285, 2006.
